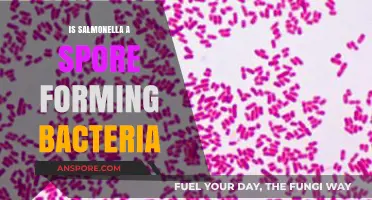
Is Salmonella Spore-Forming? Unraveling the Bacteria's Survival Mechanisms

Reishi spores, derived from the Ganoderma lucidum mushroom, have gained attention for their potential therapeutic benefits, including their role in supporting renal health. Renal disease, characterized by impaired kidney function, poses significant health challenges, and conventional treatments often focus on symptom management and slowing disease progression. Emerging research suggests that reishi spores may offer protective effects for the kidneys due to their anti-inflammatory, antioxidant, and immunomodulatory properties. Studies indicate that these spores could help reduce oxidative stress, alleviate inflammation, and improve kidney function markers in certain renal conditions. However, while preliminary findings are promising, further clinical research is needed to fully understand their efficacy and safety in managing renal disease. As interest in natural remedies grows, reishi spores present a compelling area of exploration for those seeking complementary approaches to kidney health.
What You'll Learn

Reishi spores' anti-inflammatory effects on kidneys
Chronic kidney disease affects over 800 million people globally, often driven by persistent inflammation that damages renal tissue. Reishi spores, derived from the Ganoderma lucidum mushroom, have emerged as a potential natural intervention due to their bioactive compounds, including triterpenes and polysaccharides, which exhibit anti-inflammatory properties. Research suggests these compounds can modulate inflammatory pathways, such as NF-κB and TNF-α, reducing cytokine production and mitigating kidney damage. For instance, a 2021 study in *Biomedicine & Pharmacotherapy* demonstrated that reishi spore extract significantly lowered inflammation markers in renal cells exposed to oxidative stress.
To harness reishi spores’ anti-inflammatory effects, dosage and preparation matter. Clinical studies often use 1–3 grams of spore powder daily, divided into two doses. For renal patients, starting with a lower dose (500 mg) and gradually increasing under medical supervision is advisable. Reishi spores are typically consumed as capsules, powders, or teas. However, individuals with severe kidney disease should avoid high doses, as the spores’ bioactive compounds may interact with renal function. Always consult a healthcare provider to tailor dosage to your specific condition.
Comparing reishi spores to conventional anti-inflammatory medications highlights their unique advantages. Unlike nonsteroidal anti-inflammatory drugs (NSAIDs), which can exacerbate kidney damage, reishi spores offer a gentler alternative with fewer side effects. Their ability to target multiple inflammatory pathways simultaneously sets them apart from single-action pharmaceuticals. For example, triterpenes in reishi spores not only reduce inflammation but also exhibit antioxidant effects, addressing oxidative stress—a key driver of renal disease. This dual-action mechanism makes reishi spores a promising adjunct therapy for kidney health.
Practical integration of reishi spores into a renal care regimen requires consistency and monitoring. Patients should pair supplementation with lifestyle modifications, such as a low-sodium diet and regular hydration, to maximize benefits. Avoid combining reishi spores with blood-thinning medications, as they may enhance anticoagulant effects. Additionally, sourcing high-quality spore extracts from reputable suppliers ensures purity and potency. While reishi spores are not a cure for renal disease, their anti-inflammatory properties offer a complementary approach to managing symptoms and slowing disease progression.
Can Spores Survive Anaerobic Conditions? Exploring Their Resilience and Limits
You may want to see also

Potential role in reducing renal fibrosis
Renal fibrosis, a hallmark of chronic kidney disease (CKD), involves excessive extracellular matrix deposition, leading to irreversible tissue scarring and loss of kidney function. Emerging research suggests that Reishi spores, derived from the Ganoderma lucidum mushroom, may exert antifibrotic effects by modulating key pathways involved in this process. Studies in animal models have demonstrated that Reishi spore extracts can suppress transforming growth factor-β1 (TGF-β1), a primary driver of fibrosis, while inhibiting the activation of myofibroblasts, the cells responsible for collagen production. These findings position Reishi spores as a potential adjunctive therapy for slowing CKD progression.
To harness the antifibrotic potential of Reishi spores, dosage and preparation methods are critical. Clinical trials often use standardized extracts containing 10–15% triterpenes, the bioactive compounds in Reishi spores, at doses ranging from 500 to 1,500 mg daily for adults. For individuals with CKD, starting with a lower dose (500 mg) and gradually increasing under medical supervision is advisable. It’s essential to source high-quality, certified organic Reishi spore products to ensure purity and potency, as contaminants or low-quality extracts may diminish efficacy or pose risks.
While the mechanism of action is promising, practical considerations must be addressed. Reishi spores may interact with medications commonly used in CKD management, such as immunosuppressants or anticoagulants, due to their immunomodulatory and antiplatelet effects. Patients should consult healthcare providers before incorporating Reishi spores into their regimen. Additionally, long-term safety data in humans remains limited, particularly for individuals with advanced renal disease or those on dialysis. Monitoring kidney function and adjusting dosage based on response is crucial for optimizing benefits while minimizing risks.
Comparatively, Reishi spores stand out among natural antifibrotic agents due to their multifaceted approach. Unlike single-target therapies, they modulate inflammation, oxidative stress, and cellular signaling pathways simultaneously. For instance, their ability to enhance Nrf2-mediated antioxidant responses complements their direct inhibition of fibrotic markers like SMAD3 phosphorylation. This dual action may offer broader protection against CKD progression than conventional treatments alone. However, integrating Reishi spores into a comprehensive treatment plan requires careful consideration of individual health status and existing therapies.
In conclusion, Reishi spores present a compelling natural option for mitigating renal fibrosis in CKD. Their antifibrotic mechanisms, coupled with anti-inflammatory and antioxidant properties, make them a promising adjunct to standard care. However, practical implementation demands attention to dosage, quality, and potential interactions. As research advances, Reishi spores could become a valuable tool in the fight against chronic kidney disease, offering hope for improved outcomes and quality of life.
Survival Strategies of Spore-Forming Protists: Unlocking Their Resilient Life Cycle
You may want to see also

Impact on improving kidney function markers
Reishi spores, derived from the Ganoderma lucidum mushroom, have been studied for their potential to improve kidney function markers in individuals with renal disease. Research suggests that the bioactive compounds in reishi spores, such as triterpenes and polysaccharides, may exert nephroprotective effects by reducing inflammation, oxidative stress, and fibrosis in the kidneys. For instance, a study published in the *Journal of Ethnopharmacology* found that reishi spore extract significantly lowered serum creatinine and blood urea nitrogen (BUN) levels in animal models of kidney injury, both key markers of renal function.
To harness these benefits, dosage is critical. Clinical trials often use standardized extracts containing 10–15% triterpenes, with daily doses ranging from 500 mg to 1,500 mg for adults. For instance, a 12-week study involving patients with chronic kidney disease (CKD) reported improved glomerular filtration rate (GFR) and reduced proteinuria when participants took 1,000 mg of reishi spore extract daily. However, individual responses vary, and consultation with a healthcare provider is essential to tailor dosage based on disease severity, age, and comorbidities.
While reishi spores show promise, their impact on kidney function markers should be contextualized within a holistic treatment plan. For example, combining reishi supplementation with dietary modifications, such as reducing sodium and protein intake, can amplify its benefits. Additionally, patients should monitor their kidney function regularly through blood tests to assess the effectiveness of reishi spores. Practical tips include sourcing high-quality, third-party tested supplements and avoiding concurrent use with anticoagulants, as reishi may enhance their effects.
A comparative analysis reveals that reishi spores may offer advantages over conventional therapies in certain cases. Unlike some pharmaceutical interventions, reishi spores are generally well-tolerated and have a lower risk of adverse effects. However, they are not a standalone cure for renal disease. Instead, they serve as an adjunctive therapy that may slow disease progression and improve quality of life. For older adults or those with advanced CKD, reishi spores could be particularly beneficial due to their anti-inflammatory properties, which address age-related kidney decline.
In conclusion, reishi spores hold potential for improving kidney function markers by targeting underlying mechanisms of renal damage. However, their efficacy depends on proper dosing, patient-specific factors, and integration with conventional care. As research evolves, reishi spores may become a valuable tool in managing renal disease, but their use should always be guided by medical supervision and evidence-based practices.
Mastering Spore: Strategies for Herbivore Domination and Survival
You may want to see also

Antioxidant properties for renal protection
Chronic kidney disease (CKD) affects over 800 million people globally, often driven by oxidative stress that damages renal tissues. Reishi spores, derived from the Ganoderma lucidum mushroom, contain high levels of antioxidants like triterpenes and polysaccharides, which combat this oxidative damage. Studies show these compounds neutralize free radicals, reduce lipid peroxidation, and enhance the activity of endogenous antioxidants like superoxide dismutase (SOD) and glutathione peroxidase (GPx). For instance, a 2019 animal study published in *Biomedicine & Pharmacotherapy* demonstrated that reishi spore extract significantly lowered malondialdehyde (MDA) levels, a marker of oxidative stress, in rats with induced renal injury.
To harness these benefits, consider incorporating reishi spore supplements into your regimen, but with caution. Start with a low dose of 500–1000 mg daily, preferably divided into two doses. Capsules or powdered extracts are convenient, but ensure the product is standardized to contain at least 30% polysaccharides and 2% triterpenes for efficacy. Avoid self-medication if you’re on immunosuppressants or anticoagulants, as reishi may interact with these drugs. Always consult a healthcare provider, especially if you’re over 65 or have pre-existing conditions, as renal function declines with age, making dosage adjustments critical.
Comparatively, reishi spores stand out among natural antioxidants for their dual action: they not only scavenge free radicals but also modulate inflammatory pathways that exacerbate renal damage. Unlike synthetic antioxidants, which may have side effects at high doses, reishi spores are generally well-tolerated. However, their bioavailability is lower than extracts like green tea catechins, so pairing them with vitamin C or black pepper extract can enhance absorption. For example, a pilot human study in *Phytotherapy Research* found that participants taking reishi spore extract with 50 mg of vitamin C daily experienced a 20% greater reduction in oxidative stress markers over 12 weeks.
Practical tips for integrating reishi spores into your renal protection plan include monitoring kidney function tests (e.g., serum creatinine and eGFR) every 3–6 months while using the supplement. Combine it with a low-sodium, high-fiber diet rich in fruits and vegetables to synergize antioxidant effects. Avoid excessive protein intake, as it can strain the kidneys. For those with stage 3 CKD or higher, prioritize hydration and limit reishi spore intake to 8 weeks on, 2 weeks off to prevent potential accumulation of active compounds. Lastly, opt for certified organic products to avoid heavy metal contamination, a common issue in mushroom-based supplements.
In conclusion, reishi spores offer a promising natural approach to renal protection through their potent antioxidant properties. While research is still evolving, their ability to mitigate oxidative stress and inflammation makes them a valuable adjunct therapy for CKD management. However, individualized dosing, careful monitoring, and professional guidance are essential to maximize benefits while minimizing risks. As with any supplement, consistency and lifestyle modifications are key to achieving long-term renal health.
Does the Spore Blossom Grant Flight? Exploring Its Myth and Reality
You may want to see also

Studies on reishi spores and chronic kidney disease
Reishi spores, derived from the Ganoderma lucidum mushroom, have been investigated for their potential therapeutic effects on chronic kidney disease (CKD), a condition affecting millions worldwide. Studies suggest that these spores contain bioactive compounds, such as triterpenes and polysaccharides, which may offer renal protective benefits. Research indicates that reishi spores could help mitigate inflammation, oxidative stress, and fibrosis—key factors in CKD progression. However, the efficacy and safety of reishi spores in CKD management remain under scrutiny, with most studies conducted on animal models or in vitro settings.
One notable study published in the *Journal of Ethnopharmacology* examined the effects of reishi spore extract on rats with adenine-induced chronic renal failure. The results demonstrated significant reductions in blood urea nitrogen (BUN) and serum creatinine levels, markers of kidney function, in the treated group compared to controls. Additionally, histological analysis revealed less severe renal tissue damage in the reishi-treated rats. While promising, these findings highlight the need for human clinical trials to validate these effects and determine optimal dosages.
For those considering reishi spores as a complementary therapy, it’s crucial to approach with caution. Dosage recommendations vary widely, but preliminary studies suggest 1–3 grams of reishi spore powder daily, divided into two doses. Patients should consult healthcare providers before starting any new supplement, especially if they are on medications like immunosuppressants or anticoagulants, as reishi may interact with these drugs. Age-specific considerations are also important; elderly patients with CKD may benefit from lower doses due to potential sensitivities.
Comparatively, reishi spores stand out among natural remedies for CKD due to their multifaceted mechanisms of action. Unlike single-target therapies, they address multiple pathways involved in renal dysfunction, from reducing proteinuria to improving antioxidant defenses. However, their long-term effects and safety profiles are not yet fully understood, making them a supplementary rather than primary treatment option. Patients should view reishi spores as part of a holistic approach, combining them with conventional therapies and lifestyle modifications like a low-sodium diet and regular exercise.
In conclusion, while studies on reishi spores and CKD show potential, they are far from definitive. Practical tips for incorporating reishi spores include starting with a low dose, monitoring kidney function regularly, and prioritizing high-quality, standardized supplements. As research evolves, reishi spores may emerge as a valuable adjunctive therapy for CKD, but for now, they remain a subject of cautious optimism rather than a proven solution.
Mastering Spore: Using the SetConsequenceTrait Cheat Effectively
You may want to see also
Frequently asked questions
Reishi spores are believed to have potential benefits for renal health due to their anti-inflammatory and antioxidant properties, which may help reduce kidney inflammation and oxidative stress. However, scientific evidence is limited, and consultation with a healthcare provider is essential before use.
While some studies suggest Reishi spores may support kidney function by protecting against damage and promoting detoxification, there is insufficient clinical evidence to confirm their effectiveness in treating renal disease. Always seek medical advice for proper treatment.
Reishi spores are generally considered safe, but they may interact with medications or exacerbate certain conditions. Individuals with renal disease should consult a healthcare professional before using Reishi spores to avoid potential complications.